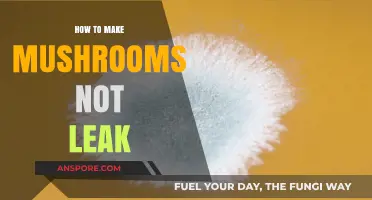
Prevent Mushrooms from Leaking: Simple Cooking Techniques for Perfect Results

Mushrooms can be a delightful addition to gardens and ecosystems, but they may also become unwelcome guests when they overpopulate or grow in undesirable areas. Understanding how to manage and control mushroom growth is essential for maintaining a balanced environment, whether in your lawn, garden, or indoor spaces. By identifying the underlying causes, such as excess moisture, organic debris, or poor drainage, you can implement targeted strategies to discourage mushroom proliferation. Methods range from simple adjustments like improving airflow and reducing water accumulation to more proactive measures like removing decaying matter or using natural deterrents. This guide will explore practical and effective ways to make mushrooms stop spreading, ensuring your space remains healthy and mushroom-free.
Explore related products
What You'll Learn
- Preventing Mushroom Growth: Control moisture, improve ventilation, and remove organic debris to stop mushrooms from growing
- Lawn Care Tips: Aerate soil, mow regularly, and avoid overwatering to deter mushroom growth in lawns
- Natural Repellents: Use vinegar, baking soda, or cinnamon to create barriers that repel mushrooms
- Garden Maintenance: Clear decaying wood, leaves, and mulch to eliminate mushroom-friendly environments
- Chemical Solutions: Apply fungicides or herbicides specifically designed to inhibit mushroom growth effectively

Preventing Mushroom Growth: Control moisture, improve ventilation, and remove organic debris to stop mushrooms from growing
Mushrooms thrive in damp, dark environments rich in organic matter, making them unwelcome guests in homes, lawns, and gardens. To halt their growth, focus on eliminating the conditions they need to flourish. Start by controlling moisture, as fungi require high humidity to develop. Fix leaky pipes, ensure proper drainage, and avoid overwatering plants. In areas prone to dampness, like basements or bathrooms, use dehumidifiers to maintain humidity levels below 50%. Regularly inspect these spaces for signs of moisture accumulation and address issues promptly.
Next, improve ventilation to disrupt the stagnant air mushrooms favor. In indoor spaces, open windows, use exhaust fans, or install air vents to promote airflow. Outdoors, trim overgrown vegetation and prune trees to allow sunlight and air to penetrate soil and mulch. For gardens, avoid overcrowding plants, as this restricts air movement and traps moisture. Even small changes, like rearranging potted plants or adding a fan to a damp corner, can significantly reduce fungal growth.
Removing organic debris is equally critical, as decaying matter provides nutrients for mushrooms. Clear dead leaves, wood chips, and grass clippings from lawns and gardens. Compost these materials properly, ensuring the pile is well-aerated and turned regularly to prevent it from becoming a breeding ground. In mulch beds, limit the depth to 2–3 inches to discourage fungal colonization. For stubborn mushroom patches, dig up and replace the affected soil, ensuring no organic debris remains.
While these measures are effective, they require consistency and vigilance. For example, after heavy rain, inspect your property for standing water and clear debris immediately. In humid climates, invest in moisture-resistant materials for basements and crawl spaces. Pair these efforts with regular monitoring—check dark corners, under sinks, and around outdoor structures for early signs of mushroom growth. By addressing moisture, airflow, and organic matter systematically, you can create an environment inhospitable to mushrooms and prevent their return.
Easy Stuffed Garlic Mushrooms Recipe: Creamy, Cheesy, and Irresistibly Delicious
You may want to see also

Lawn Care Tips: Aerate soil, mow regularly, and avoid overwatering to deter mushroom growth in lawns
Mushrooms in lawns often signal underlying soil conditions that favor fungal growth. While they aren’t inherently harmful, their presence can indicate excessive moisture, compacted soil, or organic debris—issues that disrupt lawn health. Addressing these root causes through targeted lawn care practices can effectively deter mushroom growth while improving overall turf vitality.
Aerating the soil is a cornerstone of mushroom prevention. Compacted soil restricts oxygen flow, creating an anaerobic environment where fungi thrive. Use a core aerator to remove small plugs of soil, allowing air, water, and nutrients to penetrate deeper. For best results, aerate during the growing season (early fall for cool-season grasses, late spring for warm-season grasses) and repeat annually if compaction is severe. This simple step not only discourages mushrooms but also strengthens root systems and enhances water absorption.
Regular mowing plays a dual role in mushroom management. Cutting grass to the recommended height (2.5–3.5 inches for most lawns) prevents excessive thatch buildup, a common food source for fungi. However, avoid mowing when the lawn is wet, as this can spread mushroom spores across the yard. Sharpen mower blades to ensure clean cuts, reducing stress on the grass and minimizing opportunities for fungal invasion. Consistency is key—maintain a schedule that keeps grass height within the optimal range without removing more than one-third of the blade at once.
Overwatering is a primary culprit behind mushroom outbreaks. Excess moisture creates the damp conditions fungi need to flourish. Adjust your irrigation habits by watering deeply but infrequently, aiming for 1–1.5 inches of water per week, including rainfall. Install a rain gauge to monitor levels and avoid watering during rainy periods. For automated systems, consider a smart controller that adjusts based on weather data. By keeping the soil moderately moist rather than saturated, you’ll discourage mushroom growth while promoting drought-resistant grass.
Combining these practices—aeration, proper mowing, and mindful watering—creates an environment less hospitable to mushrooms. While occasional fungi may still appear, particularly after heavy rain or in shaded areas, consistent lawn care minimizes their presence. View mushrooms as a diagnostic tool: their recurrence highlights areas needing attention, whether it’s improving drainage, reducing shade, or amending soil. With patience and precision, you can achieve a healthier lawn that naturally resists fungal intruders.
Rich Mushroom Sauce Recipe: Elevate Your Filet Mignon with Savory Perfection
You may want to see also

Natural Repellents: Use vinegar, baking soda, or cinnamon to create barriers that repel mushrooms
Mushrooms thrive in damp, organic environments, but natural repellents can disrupt their growth cycles. Vinegar, baking soda, and cinnamon each offer unique properties that make them effective barriers. Vinegar’s acetic acid alters soil pH, creating conditions mushrooms dislike, while baking soda’s alkalinity dehydrates fungal cells. Cinnamon, with its antimicrobial compounds, inhibits spore germination. These household staples provide eco-friendly alternatives to chemical fungicides, targeting mushrooms without harming plants or soil health.
To apply vinegar as a repellent, mix one part white vinegar with three parts water in a spray bottle. Thoroughly saturate the affected area, reapplying every three days or after rain. For baking soda, sprinkle a thin layer directly onto the soil or mix one tablespoon per gallon of water for a spray solution. Cinnamon works best as a powder barrier; dust it around plant bases or mushroom clusters, reapplying weekly. Each method requires consistency, as mushrooms can quickly recolonize if conditions revert to their favor.
While these repellents are safe for most plants, caution is advised. Vinegar’s acidity may harm acid-sensitive plants like azaleas or blueberries, so test a small area first. Baking soda can raise soil pH over time, potentially affecting nutrient availability for plants. Cinnamon, though generally safe, should be used sparingly to avoid overwhelming beneficial soil microbes. Always monitor treated areas and adjust applications based on plant and soil responses.
The effectiveness of these natural repellents lies in their ability to disrupt mushroom growth at multiple stages. Vinegar and baking soda target mature fungi by altering environmental conditions, while cinnamon prevents new growth by inhibiting spore development. Combining these methods—such as spraying vinegar and dusting cinnamon—can enhance results. For persistent infestations, rotate repellents to avoid fungal resistance. With patience and proper application, these natural barriers can keep mushrooms at bay while maintaining a healthy garden ecosystem.
Mastering Beech Mushrooms: Simple Steps for Growing at Home
You may want to see also
Explore related products

Garden Maintenance: Clear decaying wood, leaves, and mulch to eliminate mushroom-friendly environments
Mushrooms thrive in damp, organic-rich environments, and your garden might be the perfect breeding ground without you realizing it. Decaying wood, piled leaves, and thick mulch layers create ideal conditions for fungal growth, turning your outdoor space into a mushroom haven. To reclaim your garden, start by identifying and removing these culprits.
Begin with a thorough inspection of your garden. Look for areas where wood is rotting, such as old tree stumps, fallen branches, or decaying fencing. These are prime spots for mushrooms to take root. Use a shovel or garden fork to dig out the affected wood, ensuring you remove both visible and buried pieces. For larger stumps, consider renting a stump grinder or hiring a professional to ensure complete removal.
Next, tackle leaf piles and debris. While leaves can be beneficial as compost, when left in thick, damp piles, they become a mushroom magnet. Rake and bag leaves regularly, especially in shaded or moist areas. If you use leaves as mulch, spread them thinly to allow air circulation and prevent moisture retention. For a more permanent solution, compost leaves in a designated bin away from garden beds.
Mulch, though essential for soil health, can also contribute to mushroom growth if overapplied or left to decompose excessively. Reduce mulch thickness to no more than 2-3 inches, and avoid piling it against plant stems or tree trunks. Opt for inorganic mulches like gravel or rubber in areas prone to mushroom outbreaks. Additionally, refresh organic mulch annually to prevent it from breaking down into a mushroom-friendly substrate.
Finally, improve garden drainage to discourage mushroom growth. Mushrooms flourish in waterlogged soil, so ensure your garden has proper grading and drainage systems. Install French drains or rain barrels if necessary, and avoid overwatering plants. By combining these steps, you’ll create an environment less hospitable to mushrooms, restoring balance to your garden ecosystem.
Easy Mushroom Tikka Recipe: Electric Tandoor Cooking Guide
You may want to see also

Chemical Solutions: Apply fungicides or herbicides specifically designed to inhibit mushroom growth effectively
Fungicides and herbicides offer a direct, chemical approach to halting mushroom growth, targeting the fungal organisms responsible for their development. These substances work by disrupting key biological processes, such as cell division or nutrient absorption, effectively stunting mushroom proliferation. For instance, chlorothalonil, a broad-spectrum fungicide, is commonly applied at a rate of 2–4 pounds per 1000 square feet, depending on the severity of the infestation. It’s crucial to follow label instructions precisely, as overuse can harm surrounding vegetation and soil health. This method is particularly effective in gardens or lawns where mushrooms persist despite other interventions.
While fungicides like chlorothalonil and herbicides like glyphosate are widely used, their application requires careful consideration. Glyphosate, for example, is a non-selective herbicide that can kill all plant life, not just mushrooms. To minimize collateral damage, spot-treat affected areas rather than applying it broadly. Additionally, consider the timing of application—fungicides are most effective when applied during the early stages of mushroom growth or in conditions conducive to fungal activity, such as damp, shaded areas. Always wear protective gear, including gloves and a mask, to avoid skin and respiratory irritation.
A comparative analysis reveals that fungicides are generally more targeted than herbicides, making them a safer option for mushroom control in diverse ecosystems. Herbicides, while potent, often lack specificity, risking harm to desirable plants. For instance, a study comparing the efficacy of fungicides and herbicides in a woodland setting found that fungicides reduced mushroom populations by 85% with minimal impact on surrounding flora, whereas herbicides achieved only 70% reduction and caused noticeable damage to nearby plants. This underscores the importance of selecting the right chemical for the specific environment.
For those seeking an eco-friendly alternative within the chemical realm, consider biofungicides derived from natural sources. Products like Serenade ASO, which contains Bacillus subtilis, are effective against a range of fungal pathogens and are safe for use around children and pets. Apply at a rate of 1–2 ounces per gallon of water, spraying directly onto affected areas. While biofungicides may require more frequent applications than synthetic options, they offer a sustainable solution without compromising soil or plant health. Always test a small area first to ensure compatibility with your specific environment.
In conclusion, chemical solutions provide a potent and efficient means to inhibit mushroom growth, but their success hinges on informed application. Whether opting for synthetic fungicides, herbicides, or bio-based alternatives, understanding dosage, timing, and environmental impact is critical. By tailoring your approach to the specific conditions and goals of your space, you can effectively manage mushroom proliferation while preserving the health of your garden or lawn. Always prioritize safety and sustainability, ensuring that your chemical interventions align with long-term ecological balance.
Crispy Fried Mushrooms: A Simple, Quick, and Delicious Recipe Guide
You may want to see also
Frequently asked questions
To stop mushrooms from growing, reduce moisture by improving drainage, removing debris, and avoiding overwatering. Also, ensure proper sunlight exposure, as mushrooms thrive in damp, shady areas.
Apply a fungicide specifically designed for lawn mushrooms, or use natural remedies like vinegar or baking soda mixed with water. Regularly aerate and dethatch your lawn to discourage growth.
Allow the soil to dry out between waterings, remove any visible mushrooms, and repot the plant with fresh, well-draining soil. Avoid overwatering and ensure good air circulation.
Reduce mushroom growth in mulch by using fresh, well-aged mulch and avoiding overwatering. Rake the mulch regularly to disrupt fungal growth and improve airflow.